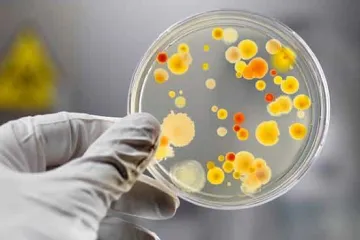

Աստղային կազմ՝ ընդդեմ Բրազիլիայի
Աստղային կազմ՝ ընդդեմ Բրազիլիայի Թրամփի անունից առաջարկել են կնքել մեծ գործարք. Լուկաշենկո
Թրամփի անունից առաջարկել են կնքել մեծ գործարք. Լուկաշենկո Արա Ֆիդանյանն ազատվել է ՆԳՆ գլխավոր քարտուղարի պաշտոնից
Արա Ֆիդանյանն ազատվել է ՆԳՆ գլխավոր քարտուղարի պաշտոնից Վերջին 15 տարիների ընթացքում ազգային թիմում չի եղել Նեյմարի մակարդակի ևս մեկ ֆուտբոլիստ. Կաֆու
Վերջին 15 տարիների ընթացքում ազգային թիմում չի եղել Նեյմարի մակարդակի ևս մեկ ֆուտբոլիստ. Կաֆու «Գրականություն» և «Հայաստանի պատմություն» քննությունները՝ էսսեի ձևաչափով
«Գրականություն» և «Հայաստանի պատմություն» քննությունները՝ էսսեի ձևաչափով Բլոգերները պարզապես հավաքվեցին Փոքր Սեյնթ Ջեյմս կղզի՝ ալիքը բռնելու համար
Բլոգերները պարզապես հավաքվեցին Փոքր Սեյնթ Ջեյմս կղզի՝ ալիքը բռնելու համար Միլիարդատերերի վրա հարստության հարկ սահմանելու կոչերը գնալով ավելի բարձր են դառնում
Միլիարդատերերի վրա հարստության հարկ սահմանելու կոչերը գնալով ավելի բարձր են դառնում Մելանյա Թրամփը շարունակում է պնդել, որ իր որդուն դեռևս անհրաժեշտ է մշտական հսկողություն
Մելանյա Թրամփը շարունակում է պնդել, որ իր որդուն դեռևս անհրաժեշտ է մշտական հսկողություն ՖԻՖԱ-ն հույս ունի, որ աշխարհի առաջնությանը մասնակցող բոլոր թիմերը կմրցեն արդար խաղի և փոխադարձ հարգանքի ոգով
ՖԻՖԱ-ն հույս ունի, որ աշխարհի առաջնությանը մասնակցող բոլոր թիմերը կմրցեն արդար խաղի և փոխադարձ հարգանքի ոգով Իսրայելի դեսպանը կանչվել է Ռուսաստանի ԱԳՆ՝ Լիբանանում իսրայելական հարվածներից RT-ի լրագրողների վիրավորման պատճառով
Իսրայելի դեսպանը կանչվել է Ռուսաստանի ԱԳՆ՝ Լիբանանում իսրայելական հարվածներից RT-ի լրագրողների վիրավորման պատճառով «Ախուրիկ» անցակետում ծառայություն են իրականացնում միայն ՀՀ ԱԱԾ սահմանապահները. ԱԱԾ տնօրեն
«Ախուրիկ» անցակետում ծառայություն են իրականացնում միայն ՀՀ ԱԱԾ սահմանապահները. ԱԱԾ տնօրեն Փարիզի Սամուելյանի Արևելյան գրախանութի աճուրդի հանված արժեքավոր որոշ գրքեր արդեն Հայաստանում են
Փարիզի Սամուելյանի Արևելյան գրախանութի աճուրդի հանված արժեքավոր որոշ գրքեր արդեն Հայաստանում են Քեզ ասում են՝ չե՞ս ուզում կռվել այս պայմաններով, ուրեմն մեկ տարի առանց մենամարտերի կնստես
Քեզ ասում են՝ չե՞ս ուզում կռվել այս պայմաններով, ուրեմն մեկ տարի առանց մենամարտերի կնստես Այսօր կսկսվի գարնանային գիշերահավասարը
Այսօր կսկսվի գարնանային գիշերահավասարը Թբիլիսիում քննարկել են երաժիշտների իրավունքները, աշխատանքային պայմանները և մշակութային քաղաքականության ապագան
Թբիլիսիում քննարկել են երաժիշտների իրավունքները, աշխատանքային պայմանները և մշակութային քաղաքականության ապագան Գրոսմայստեր Հայկ Մարտիրոսյանը հաղթանակ է տարել «19th Agzamov Memorial»-ի առաջին երկու խաղափուլերում
Գրոսմայստեր Հայկ Մարտիրոսյանը հաղթանակ է տարել «19th Agzamov Memorial»-ի առաջին երկու խաղափուլերում ԱԱԾ տնօրենը հայտարարել է, որ Եզրաս արքեպիսկոպոս Ներսիսյանը եղել է ԽՍՀՄ ՊԱԿ գործակալ
ԱԱԾ տնօրենը հայտարարել է, որ Եզրաս արքեպիսկոպոս Ներսիսյանը եղել է ԽՍՀՄ ՊԱԿ գործակալ Շրջանառվող Սահմանադրության «նախագիծը» վերջնական չէ. ՀՀ արդարադատության նախարարության պարզաբանումը
Շրջանառվող Սահմանադրության «նախագիծը» վերջնական չէ. ՀՀ արդարադատության նախարարության պարզաբանումը Իրանը հայտնել է առաջին անգամ ամերիկյան F-35 կործանիչ խոցելու մասին
Իրանը հայտնել է առաջին անգամ ամերիկյան F-35 կործանիչ խոցելու մասին Էս լրիվ գողական եք հա՞ գնում․ ԱԺ ում լարված մթնոլորտ է
Էս լրիվ գողական եք հա՞ գնում․ ԱԺ ում լարված մթնոլորտ է ՊՆ-ն մշտապես գնահատում է Հայաստանի անվտանգության հետ կապված բոլոր ռիսկերը
ՊՆ-ն մշտապես գնահատում է Հայաստանի անվտանգության հետ կապված բոլոր ռիսկերը Իսրայելում ձերբակալվել է պահեստազորային՝ Իրանի օգտին լրտեսության կասկածանքով
Իսրայելում ձերբակալվել է պահեստազորային՝ Իրանի օգտին լրտեսության կասկածանքով ՔԿՀ-ում կալանավորվածը փորձել է ինքնասպան լինել
ՔԿՀ-ում կալանավորվածը փորձել է ինքնասպան լինել Ծաղկաձորում 24 ժամ ջուր չի լինի
Ծաղկաձորում 24 ժամ ջուր չի լինի Ես չեմ ծրագրում զորքեր ուղարկել Մերձավոր Արևելք. Թրամփ
Ես չեմ ծրագրում զորքեր ուղարկել Մերձավոր Արևելք. Թրամփ Սամվել Կարապետյանը մի ամբողջ գերդաստան ունի չծառայած զավակներով, որդիներով, թոռներով. Պապիկյան
Սամվել Կարապետյանը մի ամբողջ գերդաստան ունի չծառայած զավակներով, որդիներով, թոռներով. Պապիկյան «Դիլիջան» պարկի 5 հողամասում կառուցապատման իրավունքը դադարեցնելու՝ Դատախազության հայցադիմումները ընդունվել են դատարանի վարույթ
«Դիլիջան» պարկի 5 հողամասում կառուցապատման իրավունքը դադարեցնելու՝ Դատախազության հայցադիմումները ընդունվել են դատարանի վարույթ Արաբական երկրներում հավատարմագրված ՀՀ դիվանագիտական ներկայացուցչությունների ղեկավարների հավաքը Մասկատում
Արաբական երկրներում հավատարմագրված ՀՀ դիվանագիտական ներկայացուցչությունների ղեկավարների հավաքը Մասկատում Իսրայելի պաշտպանության բանակը հայտարարել է ԻՀՊԿ ներկայացուցիչ Ալի Մոհամմադ Նաինիի մաhվան մասին
Իսրայելի պաշտպանության բանակը հայտարարել է ԻՀՊԿ ներկայացուցիչ Ալի Մոհամմադ Նաինիի մաhվան մասին Իրանը պնդում է, որ հրթիռների պակաս չունի
Իրանը պնդում է, որ հրթիռների պակաս չունի Պատերազմը կանգնեցնելու հնարավորությունը ԱՄՆ-ի ձեռքում է. Անտոնիո Գուտերեշ
Պատերազմը կանգնեցնելու հնարավորությունը ԱՄՆ-ի ձեռքում է. Անտոնիո Գուտերեշ Նեթանյահուն խոստացել է զերծ մնալ Իրանի Հարավային Պարս գազի հանքավայրի վրա հարձակումից
Նեթանյահուն խոստացել է զերծ մնալ Իրանի Հարավային Պարս գազի հանքավայրի վրա հարձակումից Մեր աղջիկները ուշ ժամի հանգիստ, ոտքով գալիս են տուն, սա Հայաստանի լավ վիճակի մասին է խոսում. Անդրանիկ Քոչարյան
Մեր աղջիկները ուշ ժամի հանգիստ, ոտքով գալիս են տուն, սա Հայաստանի լավ վիճակի մասին է խոսում. Անդրանիկ Քոչարյան Երեւանում մարզասրահի տնօրենը ծեծել է մարզչի ամուսնուն
Երեւանում մարզասրահի տնօրենը ծեծել է մարզչի ամուսնուն Կուբան պատրաստ է ԱՄՆ-ի հետ քննարկել ցանկացած հարց
Կուբան պատրաստ է ԱՄՆ-ի հետ քննարկել ցանկացած հարց Իրանը «ենթարկվում է կործանման», բայց հեղափոխությունը պահանջում է «ցամաքային բաղադրիչ». Նեթանյահու
Իրանը «ենթարկվում է կործանման», բայց հեղափոխությունը պահանջում է «ցամաքային բաղադրիչ». Նեթանյահու Ալիևը զրկել է Նախիջևանին ինքնավարությունից և «Զանգեզուրի միջանցքի» բանակցություններում դեր ունենալուց
Ալիևը զրկել է Նախիջևանին ինքնավարությունից և «Զանգեզուրի միջանցքի» բանակցություններում դեր ունենալուց Շարունակում ենք աշխատանքները՝ ընտանիքի մյուս անդամներին վերաբերելի իրավիճակներին իրավական գնահատական տալու համար
Շարունակում ենք աշխատանքները՝ ընտանիքի մյուս անդամներին վերաբերելի իրավիճակներին իրավական գնահատական տալու համար Երուսաղեմում պատմության մեջ առաջին անգամ ժամանակավորապես դադարեցվել են ժամերգությունները Սուրբ Հարության տաճարում
Երուսաղեմում պատմության մեջ առաջին անգամ ժամանակավորապես դադարեցվել են ժամերգությունները Սուրբ Հարության տաճարում Աշտարակում կասեցվել է հանրային սննդի օբյեկտի գործունեություն կասեցվել. ՍԱՏՄ
Աշտարակում կասեցվել է հանրային սննդի օբյեկտի գործունեություն կասեցվել. ՍԱՏՄ Էստոնիան մեղադրել է Ռուսաստանին` օդային տարածքի խախտման համար
Էստոնիան մեղադրել է Ռուսաստանին` օդային տարածքի խախտման համար Մակրոն. Ֆրանսիան ցանկանում է ՄԱԿ-ի Անվտանգության խորհրդում քննարկել Հորմուզի նեղուցում նավերի պաշտպանության հարցը
Մակրոն. Ֆրանսիան ցանկանում է ՄԱԿ-ի Անվտանգության խորհրդում քննարկել Հորմուզի նեղուցում նավերի պաշտպանության հարցը ԱՄՆ-ն կարագացնի Մերձավոր Արևելք ծովային հետևակայինների ուղարկումը. NBC News
ԱՄՆ-ն կարագացնի Մերձավոր Արևելք ծովային հետևակայինների ուղարկումը. NBC News Բաղդադում ԱՄՆ դեսպանատան աշխատակիցները տարհանվել են
Բաղդադում ԱՄՆ դեսպանատան աշխատակիցները տարհանվել են Ամփոփվել են «Ռոբոտների հաքաթոն»-ի արդյունքները
Ամփոփվել են «Ռոբոտների հաքաթոն»-ի արդյունքները Ապօրինի թմրաշրջանառությունից հանվեց 9 կգ մարիխուանա (տեսանյութ)
Ապօրինի թմրաշրջանառությունից հանվեց 9 կգ մարիխուանա (տեսանյութ) Մետրոպոլիտենի բնականոն երթեւեկությունը վերականգնվել է
Մետրոպոլիտենի բնականոն երթեւեկությունը վերականգնվել է ԱԺ-ում քննարկվել է մոպեդները, տրիցիկլներն ու քվադրիցիկլները պարտադիր ապահովագրության դաշտ բերելու նախագիծը
ԱԺ-ում քննարկվել է մոպեդները, տրիցիկլներն ու քվադրիցիկլները պարտադիր ապահովագրության դաշտ բերելու նախագիծը ՀՀ սնանկության դատարան 2025-ի ընթացքում մուտքագրվել է 4733 սնանկության գործ
ՀՀ սնանկության դատարան 2025-ի ընթացքում մուտքագրվել է 4733 սնանկության գործ Իրանում 19-ամյա ըմբշամարտիկի մահապատիժը նոր մտահոգությունների ալիք է բարձրացրել
Իրանում 19-ամյա ըմբշամարտիկի մահապատիժը նոր մտահոգությունների ալիք է բարձրացրել Գիտություն
 Հայտնի ո՞ր մատչելի միրգն է նպաստում քաղցկեղի կանխարգելմանը
Հայտնի ո՞ր մատչելի միրգն է նպաստում քաղցկեղի կանխարգելմանը
 Գիտնականները հավատու՞մ են այլմոլորակայինների գոյությանը. Հետաքրքիր ուսումնասիրու...
Գիտնականները հավատու՞մ են այլմոլորակայինների գոյությանը. Հետաքրքիր ուսումնասիրու...
 Ինչպես երկարացնել մարտկոցի աշխատանքը iPhone-ում
Ինչպես երկարացնել մարտկոցի աշխատանքը iPhone-ում
 Ինչպե՞ս կարող են սև խոռոչներն օգնել բացահայտելու այլմոլորակային քաղաքակրթություն...
Ինչպե՞ս կարող են սև խոռոչներն օգնել բացահայտելու այլմոլորակային քաղաքակրթություն...
 Օրական մեկ խնձոր ուտելու 5 պատճառ
Օրական մեկ խնձոր ուտելու 5 պատճառ
 Սմարթֆոնների ո՞ր բնութագրերն ու պարամետրերն են ժողովրդականություն վայելում օգտատ...
Սմարթֆոնների ո՞ր բնութագրերն ու պարամետրերն են ժողովրդականություն վայելում օգտատ...
 Ձմռանն անհրաժեշտ 7 հիմնական վիտամինները
Ձմռանն անհրաժեշտ 7 հիմնական վիտամինները
 Անգլիայում հայտնաբերել են Մեծ Բրիտանիայի ամենամեծ «դինոզավրերի մայրուղին»՝ նախապ...
Անգլիայում հայտնաբերել են Մեծ Բրիտանիայի ամենամեծ «դինոզավրերի մայրուղին»՝ նախապ...
 Եգիպտոսում հայտնաբերվել է բժշկի՝ շքեղ զարդարված 4100-ամյա դամբարան․ նա բուժել է ...
Եգիպտոսում հայտնաբերվել է բժշկի՝ շքեղ զարդարված 4100-ամյա դամբարան․ նա բուժել է ...
 Գիտնականներն առաջարկել են Կենտավրոսի Ալֆային զոնդ ուղարկելու միջոց. Այն կարող է ...
Գիտնականներն առաջարկել են Կենտավրոսի Ալֆային զոնդ ուղարկելու միջոց. Այն կարող է ...
 Ինչպես կանխարգելել մետապնևմովիրուսային (HMPV) վարակը․ Արմեն Մուրադյան
Ինչպես կանխարգելել մետապնևմովիրուսային (HMPV) վարակը․ Արմեն Մուրադյան
 10 զարմանալի գիտական փաստ Մարսի մասին
10 զարմանալի գիտական փաստ Մարսի մասին
 Ցերիումի նանոմասնիկները կպաշտպանեն առողջ բջիջները ուռուցքների ճառագայթային բուժմ...
Ցերիումի նանոմասնիկները կպաշտպանեն առողջ բջիջները ուռուցքների ճառագայթային բուժմ...
 100 տարի հետո մոլորակը կարող է կորցնել ներկայիս ֆլորայի և ֆաունայի տեսակների մին...
100 տարի հետո մոլորակը կարող է կորցնել ներկայիս ֆլորայի և ֆաունայի տեսակների մին...
 Ուսումնասիրություն. Արհեստական միսը կարող է մեծացնել դեպրեսիայի հավանականությունը
Ուսումնասիրություն. Արհեստական միսը կարող է մեծացնել դեպրեսիայի հավանականությունը
 Գիտնականը բացատրել է, թե ինչի շնորհիվ կարելի է երկարացնել կյանքը
Գիտնականը բացատրել է, թե ինչի շնորհիվ կարելի է երկարացնել կյանքը
 Ո՞ր վարակիչ հիվանդությունն, ըստ ամենայնի, կդառնա ամենամեծ խնդիրը 2025 թվականին
Ո՞ր վարակիչ հիվանդությունն, ըստ ամենայնի, կդառնա ամենամեծ խնդիրը 2025 թվականին
 Ընտանիքի միջնեկ երեխաներն ավելի հակված են համագործակցելու, քան իրենց ավագ և կրտս...
Ընտանիքի միջնեկ երեխաներն ավելի հակված են համագործակցելու, քան իրենց ավագ և կրտս...
 Թեյ և սուրճ խմողներն առավել պաշտպանված են բերանի խոռոչի, կոկորդի, գլխի և պարանոց...
Թեյ և սուրճ խմողներն առավել պաշտպանված են բերանի խոռոչի, կոկորդի, գլխի և պարանոց...
 Խոլեստերինն իջեցնելու 5 արագ միջոց
Խոլեստերինն իջեցնելու 5 արագ միջոց
 Նշվել է միլիոնավոր մարդկանց անսպասելի մահվան պատճառը
Նշվել է միլիոնավոր մարդկանց անսպասելի մահվան պատճառը
 Ռուսաստանում անցկացվում են քաղցկեղի դեմ նոր պատվաստանյութի փորձարկումներ․ Mash
Ռուսաստանում անցկացվում են քաղցկեղի դեմ նոր պատվաստանյութի փորձարկումներ․ Mash
 ՆԱՍԱ-ի զոնդը պատմության մեջ ամենամոտիկ թռիչքը կկատարի դեպի Արև
ՆԱՍԱ-ի զոնդը պատմության մեջ ամենամոտիկ թռիչքը կկատարի դեպի Արև
 Օձն ընտրել է հաջողակներին. Կենդանակերպի որ նշաններն ընդմիշտ կհիշեն 2025 թ.-ը
Օձն ընտրել է հաջողակներին. Կենդանակերպի որ նշաններն ընդմիշտ կհիշեն 2025 թ.-ը
 Բժիշկը հորդորել է շաքարը չդեմոնիզացնել, և խորհուրդ տվել, թե երբ ուտել քաղցրեղեն
Բժիշկը հորդորել է շաքարը չդեմոնիզացնել, և խորհուրդ տվել, թե երբ ուտել քաղցրեղեն
 Ի՞նչ կիբեր սպառնալիքներ պետք է սպասել 2025 թվականին
Ի՞նչ կիբեր սպառնալիքներ պետք է սպասել 2025 թվականին
 Գիտնականները գտել են վտանգավոր գիսաստղերը Երկրին մոտենալուց շատ առաջ հայտնաբերել...
Գիտնականները գտել են վտանգավոր գիսաստղերը Երկրին մոտենալուց շատ առաջ հայտնաբերել...
 53-ամյա կինը գենետիկորեն ձևափոխված խոզի օրգանի փոխպատվաստումով միակ առողջ մարդն ...
53-ամյա կինը գենետիկորեն ձևափոխված խոզի օրգանի փոխպատվաստումով միակ առողջ մարդն ...
 Ծիր Կաթինի կենտրոնում գտնվող սև անցքի մոտ առաջին անգամ կրկնակի աստղ են գտել
Ծիր Կաթինի կենտրոնում գտնվող սև անցքի մոտ առաջին անգամ կրկնակի աստղ են գտել
 Գիտնականներն առաջին անգամ արձանագրել են սև խոռոչի պայթյուն. ի՞նչ է սա նշանակում ...
Գիտնականներն առաջին անգամ արձանագրել են սև խոռոչի պայթյուն. ի՞նչ է սա նշանակում ...
Վերջին 7 օրվա
Թոփ լուրեր Թոփ 10
ամենաընթերցված
էջերը
 Իրանի դեմ հարվածների ֆոնին ՀԱԵ Ատրպատականի թեմը դադարեցրել է եկեղեցական արարողությունները
Իրանի դեմ հարվածների ֆոնին ՀԱԵ Ատրպատականի թեմը դադարեցրել է եկեղեցական արարողությունները
1
 Հայաստանն ու Իրանն աշխատում են սահմանին երկրորդ կամրջի նախագծի վրա
Հայաստանն ու Իրանն աշխատում են սահմանին երկրորդ կամրջի նախագծի վրա
2
 Եվրախորհրդարանի պատգամավորները չեն կարողացել աշխարհի քարտեզի վրա գտնել Իրանը
Եվրախորհրդարանի պատգամավորները չեն կարողացել աշխարհի քարտեզի վրա գտնել Իրանը
3
 Իրանի հարստացված ուրանի պաշարները միջուկային օբյեկտների փլատակներում են
Իրանի հարստացված ուրանի պաշարները միջուկային օբյեկտների փլատակներում են
4
 Լարիջանիի սպանությունից հետո Իրանը կասետային ռումբերով հարվածել է Թել Ավիվին
Լարիջանիի սպանությունից հետո Իրանը կասետային ռումբերով հարվածել է Թել Ավիվին
5
 Անկանխիկ ստացման եղանակի անցնելու դիմում չներկայացրած կենսաթոշակառուի համար բանկը ընտրել է ՄՍԾ-ն՝ ին...
Անկանխիկ ստացման եղանակի անցնելու դիմում չներկայացրած կենսաթոշակառուի համար բանկը ընտրել է ՄՍԾ-ն՝ ին...
6
 Եվրամիությունը չի հասկանում Իրանում պատերազմի նպատակները. Կալաս
Եվրամիությունը չի հասկանում Իրանում պատերազմի նպատակները. Կալաս
7
 ԱԹՍ-ի հարվածի հետևանքով Դուբայի միջազգային օդանավակայանի մոտ հրդեհ է բռնկել
ԱԹՍ-ի հարվածի հետևանքով Դուբայի միջազգային օդանավակայանի մոտ հրդեհ է բռնկել
8
 Մարմնամարզության տղամարդկանց հավաքականը տուն է վերադառնում
Մարմնամարզության տղամարդկանց հավաքականը տուն է վերադառնում
9
Լոնդոնից գնված հայկական եկեղեցու փեղկն ու Արշիլ Գորկու գրաֆիկական աշխատանքն առաջիկա օրերին կցուցադրվ...
Լոնդոնից գնված հայկական եկեղեցու փեղկն ու Արշիլ Գորկու գրաֆիկական աշխատանքն առաջիկա օրերին կցուցադրվ...
10



